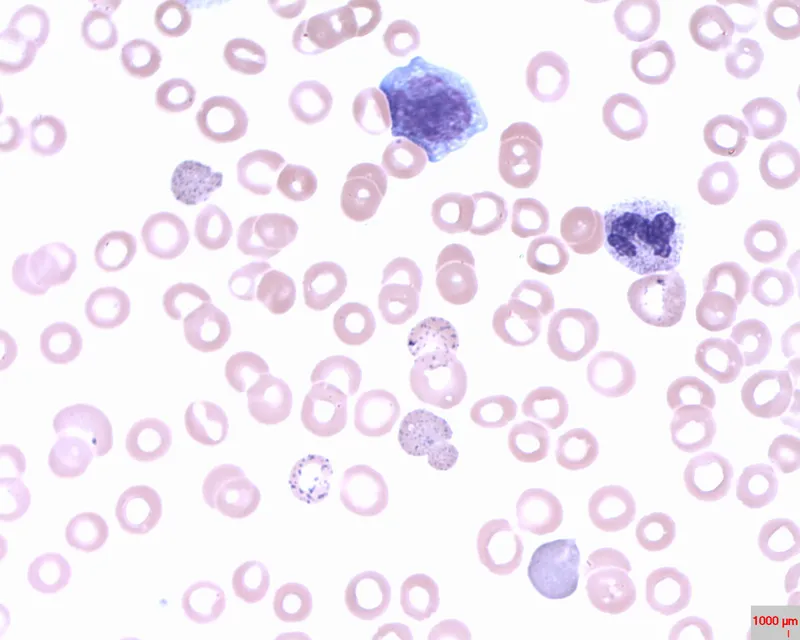
Peripheral blood smear in Thalassemia

Thalassemias: The Basics - Globin Chain Game
- Quantitative defect: ↓ synthesis of one or more globin chains, leading to microcytic hypochromic anemia.
- Normal Adult Hb: HbA ($\alpha_2\beta_2$ >95%), HbA2 ($\alpha_2\delta_2$ 2-3.5%), HbF ($\alpha_2\gamma_2$ <1%).
- Types (gene locus):
- α-Thalassemia: Defective α-chain synthesis (Chr 16, 4 α-genes).
- β-Thalassemia: Defective β-chain synthesis (Chr 11, 2 β-genes).
- Pathophysiology: Globin chain imbalance → unpaired chains precipitate → RBC damage → ineffective erythropoiesis & hemolysis.
⭐ Hb Bart's ($\gamma_4$) is characteristic of severe α-thalassemia (hydrops fetalis).
Alpha Thalassemias - Alpha's Missing Acts
- Caused by deletions of α-globin genes (HBA1, HBA2) on chromosome 16. 📌 Alpha has 16 candles. Severity depends on number of deletions (1-4).
- Clinical Spectrum & Genotypes:
- Diagnosis: ↓MCV, ↓MCH, normal/↑RBC count. Peripheral smear: target cells, poikilocytosis. Hb electrophoresis (detects HbH, Hb Bart's). Genetic testing (DNA analysis) is confirmatory.
⭐ Hb Bart's (γ4) has an extremely high oxygen affinity, leading to severe tissue hypoxia and is the most severe form, causing hydrops fetalis.
Beta Thalassemias - Beta's Broken Beats
- Pathophysiology: Deficient $\beta$-globin chain synthesis (HBB gene, Chr 11). Excess $\alpha$-chains precipitate $\rightarrow$ ineffective erythropoiesis & hemolysis.
- Types:
- Minor (Trait): Heterozygous ($\beta/\beta^+$ or $\beta/\beta^0$). Mild microcytic anemia. Key: $\uparrow$HbA2 (>3.5%).
- Intermedia: Moderate severity; transfusion needs vary.
- Major (Cooley's Anemia): Homozygous ($\beta^0/\beta^0$). Severe anemia (Hb <7 g/dL), massive hepatosplenomegaly, "hair-on-end" skull X-ray. Requires lifelong transfusions & iron chelation.
- Diagnosis: Hb electrophoresis (Major: $\uparrow\uparrow$HbF, $\uparrow$HbA2, $\downarrow\downarrow$/absent HbA). 
⭐ In Beta Thalassemia Major, HbF is markedly elevated, often >90%, as a compensatory mechanism for absent HbA production after birth.
Diagnosis & DDx - Spotting the Suspects
- Suspicion: Microcytic (MCV <80 fL), hypochromic anemia.
- Key Labs:
- CBC: ↓Hb, ↓MCV, ↓MCH. RDW normal/↑.
- Peripheral Smear (PS): Target cells, basophilic stippling, anisopoikilocytosis.
- Reticulocyte count: Normal or ↑ (ineffective erythropoiesis).
- Confirmatory: Hb Electrophoresis / HPLC.
- β-Thal Major: ↑↑HbF (often >90%), HbA absent/markedly ↓.
- β-Thal Trait: ↑HbA2 (>3.5% - 7%).
- α-Thal (HbH disease): HbH (β4) bodies detected.
- DDx (Microcytic Anemias): Iron Deficiency Anemia (IDA; ↓Ferritin, ↑TIBC), Anemia of Chronic Disease (ACD), Sideroblastic anemia, Lead poisoning.
- 📌 Mentzer Index: $MCV/RBC < \textbf{13}$ suggests Thalassemia trait.
⭐ In β-thalassemia trait, HbA2 levels are characteristically elevated, typically between 3.5% and 7%.
Management & Complications - Taming the Trouble
- Core Management: Lifelong transfusions, meticulous iron chelation. HSCT offers cure.
- Transfusion Goal: Pre-transfusion Hb 9-10.5 g/dL (leukoreduced PRBCs).
- Chelation Details: Start if ferritin >1000 ng/mL or 10-20 transfusions. Key agents: Deferoxamine, Deferasirox, Deferiprone.
- Iron Overload Complications: Cardiac (failure, arrhythmias - main death cause), endocrine (hypogonadism, DM), hepatic (fibrosis).
- Other Key Complications: Skeletal ("chipmunk facies"), gallstones, infections (Yersinia with deferoxamine).
⭐ Cardiac siderosis is the primary cause of mortality in transfusion-dependent thalassemia.
High‑Yield Points - ⚡ Biggest Takeaways
- α-Thalassemia: Caused by gene deletions. Hb Bart's (γ4) leads to hydrops fetalis; HbH disease (β4) causes chronic hemolytic anemia.
- β-Thalassemia: Results from point mutations. β-Thalassemia Major (Cooley's Anemia) is severe and transfusion-dependent; β-Thalassemia Minor shows characteristic ↑HbA2.
- Pathophysiology: Imbalanced globin chain synthesis leads to ineffective erythropoiesis, hemolysis, and subsequent iron overload.
- Clinical features: Severe microcytic hypochromic anemia, hepatosplenomegaly, and characteristic skeletal deformities (e.g., "crew-cut" skull X-ray).
- Diagnosis: Primarily by HPLC or Hb electrophoresis (↑HbF in β-Major, ↑HbA2 in β-Minor). Peripheral smear shows target cells.
- Management: Regular blood transfusions and iron chelation therapy are the mainstays of treatment for severe forms.
Unlock the full lesson and continue reading
Signup to continue reading this lesson and unlimited access questions, flashcards, AI notes, and more